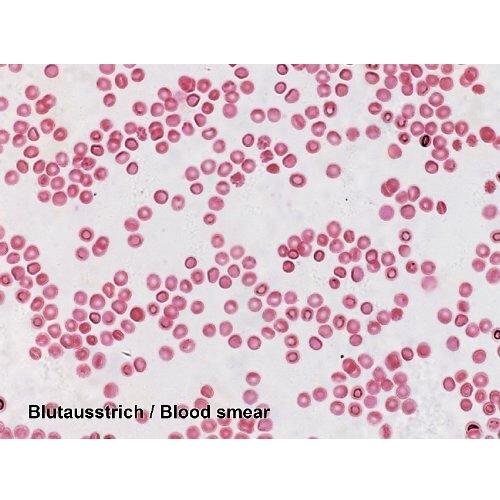
product image

Patrocinado Este sitio contiene enlaces de afiliados por los cuales podríamos recibir una compensación. Más información
69.90 EUR
69.90 EUR
06-05-2025 17:14:59
| Length | 9.055118101 Pulgadas |
|---|---|
| VRN del minorista | NL851528144B01 |